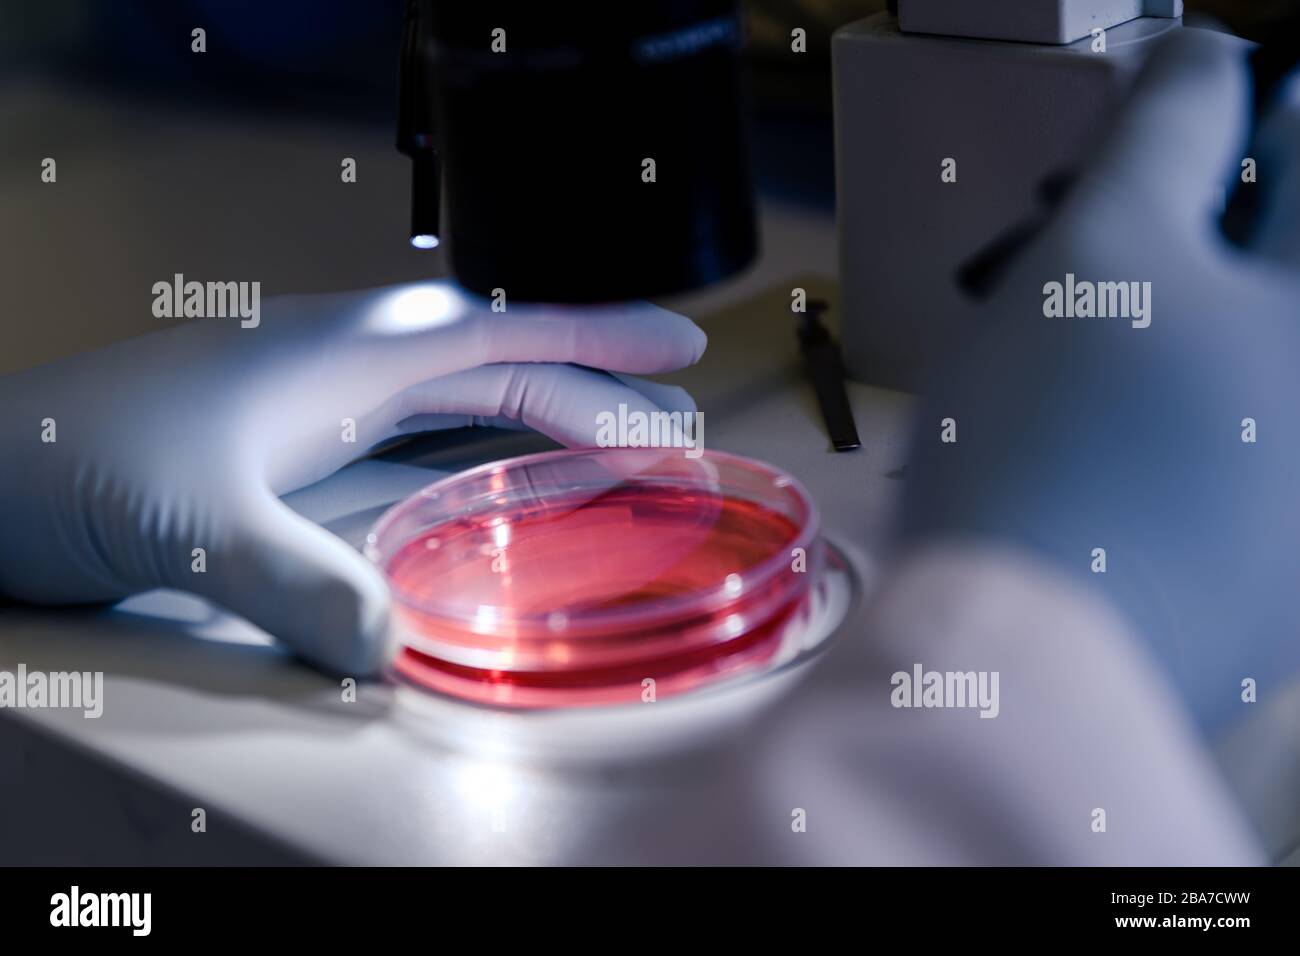
Nahaufnahme einer Person, die Coronavirus-Partikel mit einem untersucht Mikroskop Stockfoto

Schnellfilter:
Ebola virus partikel Stockfotos & Bilder

RFPEY8NW–Ebola virus Partikel im Blut, computer Abbildung. Dieses Virus ist die Ursache der Krankheit Ebola Virus bei Menschen und Primaten. Es ist eine schwere und oft tödliche Krankheit mit Symptomen wie Fieber, Müdigkeit, Muskelschmerzen, Erbrechen, Durchfall und Blutungen (innere Blutungen). Es gibt keine Heilung für die Krankheit, aber drei Viertel der Patienten wiederhergestellt werden kann, wenn ausreichende medizinische Unterstützung.

RM2K5E6YF–Eingefärbte Rasterelektronenmikroskopie von filamentösen Ebola-Viruspartikeln (blau), die aus einer chronisch infizierten VERO E6-Zelle (gelb-grün) aufkeimen. Kredit: National Institute of Allergy and Infectious Diseases, NIH

RFF3H841–Filamentösen Ebola-Virus-Partikel, die angehende aus einer chronisch-infizierten VERO E6 Zelle

RFF3H840–Filamentösen Ebola-Virus-Partikel, die angehende aus einer chronisch-infizierten VERO E6 Zelle

RFEXFB55–Filamentösen Ebola-Virus-Partikel (rot gefärbt) angehende aus einer chronisch-infizierten VERO E6 Zelle (farbige blau)

RMF7N93R–Produziert vom nationalen Institut der Allergie und Infektionskrankheiten (NIAID), unter einem sehr hohen Vergrößerung, diese Digital-eingefärbte Scanning Electron Micrograph (SEM) schildert filamentösen Ebola virus angehende Partikel von der Oberfläche einer Vero Zelle der afrikanischen grünen Affen Niere Epithelzellen.

RME6JJKD–Mikroskopische Ansicht des Ebola-Virus. Eingefärbte scanning Electron Schliffbild von filamentösen Ebola-Virus-Partikel befestigt und angehende aus einer chronisch infizierten VERO E6-Zelle.

RME6JJKC–Mikroskopische Ansicht des Ebola-Virus. Eingefärbte scanning Electron Schliffbild von filamentösen Ebola-Virus-Partikel befestigt und angehende aus einer chronisch infizierten VERO E6-Zelle.

RM2YD9RK9–Kolorierter Transmissions-Elektronenmikrograph von Ebola-Virus-Partikeln Gold fand sowohl extrazellulär und Knospen von chronisch infizierten afrikanischen grünen Affen Nierenzellen blau. 2024 : Experimentelle Ebola-Impfstoffe fanden sicher und in der Lage, Immunantworten bei gesunden Erwachsenen zu produzieren. Ebola Virus Partikel 016867 187

RFECF1C0–Eingefärbte scanning Electron Schliffbild von filamentösen Ebola-Virus-Partikel (blau) angehende von chronisch infizierten VERO E6 c

RM3B4GG73–24. November 2014 - Atlanta, Vereinigte Staaten von Amerika - mikroskopische Ansicht des Ebola-Virus-Partikels. Farbige Rasterelektronenmikrographie filamentöser Ebola-Viruspartikel. (Kreditbild: © NIAID via ZUMA Wire)

RM3AAEM28–8. August 2014 - Atlanta, GA, Vereinigte Staaten von Amerika - mikroskopische Ansicht des Ebola-Virus. Farbiges Rasterelektronenmikrogramm filamentöser Ebola-Viruspartikel, die an einer chronisch infizierten VERO-E6-Zelle gebunden sind und aus ihr heraus wachsen. (Kreditbild: © NIAID via ZUMA Wire)

RM2JHDY3J–Ghana hat die ersten beiden Fälle des tödlichen Marburg-Virus bestätigt, einer hochinfektiösen Krankheit in derselben Familie wie das Ebola-Virus. Beide Patienten starben im Krankenhaus in der Ashanti-Region im Süden des Landes. 18. Juli 2022 Eine einzigartige Zusammenstellung aus 4 Rasterelektronenmikroskopischen Aufnahmen von Marburg-Viruspartikeln, die aus infizierten VERO E6-Zellen gewonnen wurden. Hochauflösende (ca. 70MB cm bei 300dpi; 40 cm) Dateien, die nach Wunsch zu Einzelbildern bearbeitet werden können. Eine optimierte und verbesserte, einzigartige Composite-Version von 4 Rasterelektronenmikrographen-Bildern, Quelle: NIAID / Alamy Live News

RM3AAEM2Y–17. Juni 2014 - Atlanta, GA, Vereinigte Staaten von Amerika - mikroskopische Ansicht des Ebola-Virus. Farbiges Rasterelektronenmikrogramm filamentöser Ebola-Viruspartikel, die an einer chronisch infizierten VERO-E6-Zelle gebunden sind und aus ihr heraus wachsen. (Kreditbild: © NIAID via ZUMA Wire)

RFPEY8P0–Ebola virus Partikel im Blut, computer Abbildung. Dieses Virus ist die Ursache der Krankheit Ebola Virus bei Menschen und Primaten. Es ist eine schwere und oft tödliche Krankheit mit Symptomen wie Fieber, Müdigkeit, Muskelschmerzen, Erbrechen, Durchfall und Blutungen (innere Blutungen). Es gibt keine Heilung für die Krankheit, aber drei Viertel der Patienten wiederhergestellt werden kann, wenn ausreichende medizinische Unterstützung.

RM3B4GG6H–11. Dezember 2014 - Atlanta, Vereinigte Staaten von Amerika - mikroskopische Ansicht des Ebola-Virus aus einer Blutprobe des Mali-Opfers. Farbiges Rasterelektronenmikrogramm filamentöser Ebola-Viruspartikel, die an einer chronisch infizierten VERO-E6-Zelle gebunden sind und aus ihr heraus wachsen. (Kreditbild: © NIAID via ZUMA Wire)

RFF3H85X–Filamentösen Ebola-Virus-Partikel (farbige blau) angehende aus einer chronisch-infizierten VERO E6 Zelle (farbige gelb)

RFEXFB53–Filamentösen Ebola-Virus-Partikel (farbige blau) angehende aus einer chronisch-infizierten VERO E6 Zelle (farbige gelb)

RM3B4GCY1–15. Dezember 2014 - Atlanta, GA, Vereinigte Staaten von Amerika - mikroskopische Ansicht des Ebola-Virus aus einer Blutprobe des Mali-Opfers. Farbiges Rasterelektronenmikrogramm filamentöser Ebola-Viruspartikel, die an einer chronisch infizierten VERO-E6-Zelle gebunden sind und aus ihr heraus wachsen. (Kreditbild: © NIAID via ZUMA Wire)

RM3C68W34–26. Mai 2020, Fredrick, Maryland, USA: Farbiges Rasterelektronenmikroskop einer toten Zelle, die stark mit SARS-COV-2-Viruspartikeln (gelb) infiziert ist, isoliert aus einer Patientenprobe. Neue Forschungsergebnisse zeigen, dass REMDESIVIR, eine medikamentöse Behandlung, die Erholungszeit für Menschen mit Coronavirus verkürzt. Der britische Gesundheitsminister Hancock sagte, es sei wahrscheinlich der größte Schritt nach vorn in der Behandlung des Coronavirus seit Beginn der Krise. Remdesivir ist ein antivirales Arzneimittel, das gegen Ebola angewendet wurde. Forscher es gibt genug Beweise, um seine Verwendung bei ausgewählten COVID-19 Krankenhauspatienten zu genehmigen.The

RM2YD9PW3–Colorierte Transmissions-Elektronenmikrograph von Ebola-Virus-Partikeln Gold fand sowohl extrazellulär als auch Knospen von chronisch infizierten afrikanischen grünen Affen-Nierenzellen grüne Ebola-Virus-Partikel 016867 107

RF2R727DX–Ebola virus Partikel, computer Abbildung. Ebola Virus (EBOV) ist die Ursache der Krankheit Ebola Virus bei Menschen und Primaten. Es ist ein Seve

RMHEP2AW–Kol. Heath Roscoe, Recht, Kommandeur der 36. Ingenieur-Brigade in Fort Hood, Texas, Soldaten der 615th Ingenieur Gesellschaft, 4. Pionier-Bataillon 36. Ing. Bde., aus Fort Carson, Colorado, um ihre Fortschritte zu sehen, auf die Reparatur der Freeport-Straße nahe dem Hafen, Monrovia, Liberia, 14. Januar 2015, zur Unterstützung der Operation United Hilfe besucht. Roscoe eingecheckt am Soldaten und dankte ihnen für ihre harte Arbeit. Die Soldaten trugen Masken zum Schutz vor Staub und Schmutz Partikel aus dem Bau. Betrieb United Hilfe ist ein US-Verteidigungsministerium Betrieb in Liberia, pr

RFPEY8NX–Ebola virus Partikel im Blut, computer Abbildung. Dieses Virus ist die Ursache der Krankheit Ebola Virus bei Menschen und Primaten. Es ist eine schwere und oft tödliche Krankheit mit Symptomen wie Fieber, Müdigkeit, Muskelschmerzen, Erbrechen, Durchfall und Blutungen (innere Blutungen). Es gibt keine Heilung für die Krankheit, aber drei Viertel der Patienten wiederhergestellt werden kann, wenn ausreichende medizinische Unterstützung.

RMCWBW64–Ebola-Virionen (Viruspartikel). Ebola hämorrhagisches Fieber ist eine schwere, oft tödliche Erkrankung bei Menschen, Affen, Gorillas, und

RF2H6FW5F–3D Darstellung von Viruspartikeln und Virusstrukturen auf violettem Hintergrund mit Kopierraum

RMC13JND–Ebola-Virionen (Viruspartikel). Ebola-Fieber ist eine schwere, oft tödliche Krankheit bei Menschen, Affen, Gorillas und Schimpansen, die sporadisch seit ihrer erstmaligen Erfassung im Jahre 1976 erschienen ist.

RFEXFB57–Filamentösen Ebola-Virus-Partikel (grün) angehende aus einer chronisch-infizierten VERO E6 Zelle (farbige gelb)

RMEX7H3E–Filamentösen Ebola-Virus-Partikel (farbige blau) angehende aus einer chronisch-infizierten VERO E6 Zelle

RMR62EAD–Marburg Virus Teilchen (in blau) und Sperma aus der Tubuli seminiferi Tubulus, einem Ort der immune Privilege und Spermienproduktion im Hoden, einer nicht-menschlichen Primaten, Marburg virus Infektion überlebt.

RF2R727ED–Ebola virus Partikel, computer Abbildung. Ebola Virus (EBOV) ist die Ursache der Krankheit Ebola Virus bei Menschen und Primaten. Es ist ein Seve

RFPEY8NG–Ebola virus Partikel im Blut, computer Abbildung. Dieses Virus ist die Ursache der Krankheit Ebola Virus bei Menschen und Primaten. Es ist eine schwere und oft tödliche Krankheit mit Symptomen wie Fieber, Müdigkeit, Muskelschmerzen, Erbrechen, Durchfall und Blutungen (innere Blutungen). Es gibt keine Heilung für die Krankheit, aber drei Viertel der Patienten wiederhergestellt werden kann, wenn ausreichende medizinische Unterstützung.

RF2R727E9–Ebola virus Partikel, computer Abbildung. Ebola Virus (EBOV) ist die Ursache der Krankheit Ebola Virus bei Menschen und Primaten. Es ist ein Seve

RFPEY8NH–Ebola virus Partikel im Blut, computer Abbildung. Dieses Virus ist die Ursache der Krankheit Ebola Virus bei Menschen und Primaten. Es ist eine schwere und oft tödliche Krankheit mit Symptomen wie Fieber, Müdigkeit, Muskelschmerzen, Erbrechen, Durchfall und Blutungen (innere Blutungen). Es gibt keine Heilung für die Krankheit, aber drei Viertel der Patienten wiederhergestellt werden kann, wenn ausreichende medizinische Unterstützung.

RF2DFD29A–Kolorierte Transmissionselektronenmikrographie von Ebola-Viruspartikeln (grün) gefunden Sowohl als extrazelluläre Partikel als auch als angehende Partikel aus chronisch

RFPEY8NR–Ebola virus Partikel im Blut, computer Abbildung. Dieses Virus ist die Ursache der Krankheit Ebola Virus bei Menschen und Primaten. Es ist eine schwere und oft tödliche Krankheit mit Symptomen wie Fieber, Müdigkeit, Muskelschmerzen, Erbrechen, Durchfall und Blutungen (innere Blutungen). Es gibt keine Heilung für die Krankheit, aber drei Viertel der Patienten wiederhergestellt werden kann, wenn ausreichende medizinische Unterstützung.

RF2DFD2AA–Eingefärbte Rasterelektronenmikroskopie von Ebola-Viruspartikeln (blau), die an der Oberfläche einer infizierten VERO-E6-Zelle (gelb) aufkeimend und befestigt sind.

RFPEY8NY–Ebola virus Partikel im Blut, computer Abbildung. Dieses Virus ist die Ursache der Krankheit Ebola Virus bei Menschen und Primaten. Es ist eine schwere und oft tödliche Krankheit mit Symptomen wie Fieber, Müdigkeit, Muskelschmerzen, Erbrechen, Durchfall und Blutungen (innere Blutungen). Es gibt keine Heilung für die Krankheit, aber drei Viertel der Patienten wiederhergestellt werden kann, wenn ausreichende medizinische Unterstützung.

RF2DFD2AB–Eingefärbte Rasterelektronenmikroskopie von Ebola-Viruspartikeln (grün), die an der Oberfläche infizierter VERO-E6-Zellen (blau) aufkeimend und befestigt sind. Ima

RFPEY8P1–Ebola virus Partikel im Blut, computer Abbildung. Dieses Virus ist die Ursache der Krankheit Ebola Virus bei Menschen und Primaten. Es ist eine schwere und oft tödliche Krankheit mit Symptomen wie Fieber, Müdigkeit, Muskelschmerzen, Erbrechen, Durchfall und Blutungen (innere Blutungen). Es gibt keine Heilung für die Krankheit, aber drei Viertel der Patienten wiederhergestellt werden kann, wenn ausreichende medizinische Unterstützung.

RFJMXDCT–Ebola-Virus-Partikel, Computer Bild. Das Ebola-Virus (EBOV) ist die Ursache des Ebola-Virus bei Menschen und nichtmenschlichen Primaten. Es ist eine schwere und häufig tödliche Krankheit mit Symptomen wie Fieber, Müdigkeit, Muskel Schmerzen, Erbrechen, Durchfall und Blutungen (innere Blutungen). Es gibt keine Heilung für die Krankheit, aber drei Viertel der Patienten kann zurückgewinnen, wenn ausreichende medizinische Betreuung zur Verfügung gestellt.

RF2DFD2A1–Rasterelektronenmikrographie von filamentösen Ebola-Virus-Partikeln, die an und angeschlossen sind Knospen von chronisch infizierten VERO E6-Zellen (15.000fache Vergrößerung)

RFJMXDCN–Ebola-Virus-Partikel, Computer Bild. Das Ebola-Virus (EBOV) ist die Ursache des Ebola-Virus bei Menschen und nichtmenschlichen Primaten. Es ist eine schwere und häufig tödliche Krankheit mit Symptomen wie Fieber, Müdigkeit, Muskel Schmerzen, Erbrechen, Durchfall und Blutungen (innere Blutungen). Es gibt keine Heilung für die Krankheit, aber drei Viertel der Patienten kann zurückgewinnen, wenn ausreichende medizinische Betreuung zur Verfügung gestellt.

RF2DFD29R–Koloriertes Rasterelektronenmikrograph von Filamentous. Ebola-Viruspartikel (grün), die an eine chronisch infizierte VERO-E6-Zelle gebunden sind

RFJMXDCY–Ebola-Virus-Partikel, Computer Bild. Das Ebola-Virus (EBOV) ist die Ursache des Ebola-Virus bei Menschen und nichtmenschlichen Primaten. Es ist eine schwere und häufig tödliche Krankheit mit Symptomen wie Fieber, Müdigkeit, Muskel Schmerzen, Erbrechen, Durchfall und Blutungen (innere Blutungen). Es gibt keine Heilung für die Krankheit, aber drei Viertel der Patienten kann zurückgewinnen, wenn ausreichende medizinische Betreuung zur Verfügung gestellt.

RF2DFD29Y–Koloriertes Rasterelektronenmikrograph von filamentösen Ebola-Viruspartikeln, die aus einer chronisch infizierten VERO E6-Zelle entstehen (35.000-fache Vergrößerung).

RFJMXDCR–Ebola-Virus-Partikel, Computer Bild. Das Ebola-Virus (EBOV) ist die Ursache des Ebola-Virus bei Menschen und nichtmenschlichen Primaten. Es ist eine schwere und häufig tödliche Krankheit mit Symptomen wie Fieber, Müdigkeit, Muskel Schmerzen, Erbrechen, Durchfall und Blutungen (innere Blutungen). Es gibt keine Heilung für die Krankheit, aber drei Viertel der Patienten kann zurückgewinnen, wenn ausreichende medizinische Betreuung zur Verfügung gestellt.

RFPCW3X5–Ebola virus Partikel, computer Abbildung. Ebola Virus (EBOV) ist die Ursache der Krankheit Ebola Virus bei Menschen und Primaten. Es ist eine schwere und oft tödliche Krankheit mit Symptomen wie Fieber, Müdigkeit, Muskelschmerzen, Erbrechen, Durchfall und Blutungen (innere Blutungen). Es gibt keine Heilung für die Krankheit, aber drei Viertel der Patienten wiederhergestellt werden kann, wenn ausreichende medizinische Unterstützung. Hier, auf der Oberfläche des Virus gesehen, sind trimeric transmembrane Glykoproteine (lumpy), Eintrag des Virus in die Wirtszelle zu erleichtern.

RF2DFD29J–Koloriertes Rasterelektronenmikrograph von Filamentous. Ebola-Viruspartikel (rot) befestigt und keimend aus. Eine chronisch infizierte VERO E6-Zelle (blu

RFPCW3X4–Ebola virus Partikel, computer Abbildung. Ebola Virus (EBOV) ist die Ursache der Krankheit Ebola Virus bei Menschen und Primaten. Es ist eine schwere und oft tödliche Krankheit mit Symptomen wie Fieber, Müdigkeit, Muskelschmerzen, Erbrechen, Durchfall und Blutungen (innere Blutungen). Es gibt keine Heilung für die Krankheit, aber drei Viertel der Patienten wiederhergestellt werden kann, wenn ausreichende medizinische Unterstützung. Hier, auf der Oberfläche des Virus gesehen, sind trimeric transmembrane Glykoproteine (lumpy), Eintrag des Virus in die Wirtszelle zu erleichtern.